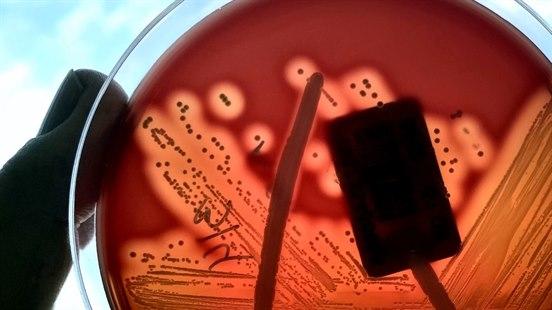
Fotoet viser en petriskål og to fingre til en person som holder skålen i hånda. Kolonier av gruppe A streptokokker har vokst på blodagar-vekstmedium.

Halsbetennelse med streptokokker
Streptokokk-bakterier kan forekomme som del av den vanlige bakterieveksten i halsen. Men de kan også forårsake halsbetennelser. Dette gir halssmerter, ubehag ved svelging og sykdomsfølelse.
Sist oppdatert:
6. nov. 2025
Hva er halsbetennelse med streptokokker?
Streptokokker er den vanligste årsaken til bakteriell halsbetennelse. Som oftest starter sykdommen akutt med sykdomsfølelse, sår hals, svelgsmerter, hovne og ømme halsglandler. De fleste får feber (38 - 41° C). Hodepine er vanlig også. Som oftest er det fravær av vanlige forkjølelsessymptomer som rennende nese og hoste. Men av og til kan streptokokkhalsbetennelse også oppstå som komplikasjon av en virusutløst halsbetennelse/forkjølelse.
Hos små barn kan symptomene være utydelige. De kan ha vondt i magen, kaste opp eller bli slappe og la være å spise. Iblant kan øreverk være et symptom.
Forekomst
De fleste halsbetennelser skyldes virus. Rundt én av fem halsbetennelser skyldes streptokokker, som er den vanligste årsaken til bakteriell halsbetennelse. Sykdommen er hyppigst om høsten og om vinteren. Det kan være små utbrudd hvor mange i en barnehage eller på en skole blir smittet.
Årsaker
Som oftest forårsakes streptokokkhalsinfeksjon av såkalte gruppe A betahemolytiske streptokokker (GAS), men andre betahemolytiske streptokokker kan forårsake et liknende sykdomsbilde. Bakteriene kan spre seg fra person til person ved nærdråpesmitte eller kontaktsmitte. I en frisk befolkning kan denne bakterien påvises hos rundt én av ti av de undersøkte. Disse personene har altså bakteriene i svelget uten at de blir syke av det, noe som kalles bærertilstand. Ved en infeksjon trenger bakteriene inn i slimhinnene og medfører en kraftig betennelse. Matsmitte forekommer også, men er forholdsvis sjelden. Denne smittemåten kan gi utbrudd av streptokokkhalsinfeksjon i f.eks. militærleirer eller institusjoner.
Diagnosen
Sykehistorien har typiske trekk hos voksne, ungdommer og barn over fem år. Disse er akutt oppstart av følgende symptomer og tegn (Centor-kriteriene) hos en person med sår hals og moderat til alvorlig sykdomsfølelse:
- Feber over 38,5°C
- Belegg eller pusspropper på tonsillene
- Forstørrede og ømme halsglandler
- Fravær av hoste
Når alle fire kriteriene er til stede, anbefaler norske retningslinjer å vurdere antibiotikabehandling uten videre testing. Dersom to eller tre av kriteriene er oppfylt, kan det være hensiktsmessig å ta laboratorieprøver. Ved bare ett kriterium og ellers god allmenntilstand, er det vanligvis ikke nødvendig med prøvetaking eller behandling med det første.
Hos barn under fem år er ofte sykdomsbildet mer uklart. Småbarn med streptokokkhalsinfeksjon kan for eksempel ha bare en lett betennelse i halsen og/eller matvegring, feber, magesmerter, kvalme og brekninger.
Selv om diagnosen av streptokokkhalsinfeksjon er enkel ved typisk sykdomsbilde, kan det å stille riktig diagnose noen ganger være vanskelig. Målsetningen er å unngå overbehandling med antibiotika, men samtidig å sikre at de som har behov for behandling, får den.
Dersom legen er i tvil, kan to prøver være verdifulle:
- En hurtigtest fra halsen kan i løpet av få minutter, med ganske bra sikkerhet, fastslå om personen har GAS-streptokokker i halsen ("streptest"). Det benyttes en bomullspinne som strykes over halsmandlene/svelget. I løpet av noen få minutter kan resultatet avleses.
- En blodprøve, CRP, som også gir svar i løpet av få minutter, er noen ganger et nyttig hjelpemiddel for å vurdere om det er mer sannsynlig med virus- eller bakterieinfeksjon.
Forhold som kan gi grunnlag for feilvurderinger er for eksempel mandelsteiner som mistolkes for å være pussbelegg på tonsillene, positiv streptest hos en person som er GAS-bærer, men har en virusutløst halsinfeksjon eller en CRP-prøve som er tatt veldig tidlig eller -sent i forløpet, med mer. Allmenntilstanden er avgjørende for valg av videre tiltak og -behandling. Det er legens oppgave å tolke sykehistorien, kliniske funn og eventuelle prøvesvar.
Behandling
Hvile og avlastning er fornuftig. Febernedsettende og smertestillende medikamenter som paracetamol kan benyttes ved behov. Milde streptokokkinfeksjoner med sår hals uten feber kan man se an i noen dager uten antibiotika. Disse kan bli bedre av seg selv. Men dersom legen konkluderer med moderat til alvorlig halsinfeksjon med streptokokker, er det vanlig å behandle med antibiotika. Penicillin har best effekt, men det finnes alternativer som kan benyttes. Ved halsbetennelse forårsaket av andre bakterier enn streptokokker vurderes behov for behandling basert på underliggende årsak i hvert enkelt tilfelle.
Forløp og prognose
De fleste blir bedre etter én uke, uavhengig av antibiotikabehandling. Men behandlingen forkorter varighet og alvorlighetsgrad av symptomene noe og forebygger senkomplikasjoner som kan oppstå. Uteblitt effekt av antibiotikabehandling eller tilbakefall etter avsluttet behandling ses hos omtrent én av ti.
Personer som behandles med antibiotika, men som ikke er bedre innen tre til fem dager, bør kontakte legen på ny. Det kan foreligge andre sykdommer som skal ha annen behandling, eller det kan være at bakteriene ikke er følsomme mot antibiotikakuren som er valgt.
Om utviklingen ikke er som forventet og vedkommende blir dårligere, bør hen ta kontakt med helsetjenesten på ny. Økende feber og -hevelse på halsen, eller problemer med å gape kan være tegn på utvikling av en halsbyll. Det dannes da en byll i vevet rundt mandelen, og denne må tømmes for puss.
Giktfeber og nyrebetennelse kan være komplikasjoner av en ubehandlet streptokokkbetennelse (se senkomplikasjoner til halsbetennelse). Slike sykdommer var hyppigere i gamle dager og er heldigvis sjeldne i disse tider. Vi regner at en viktig forklaring på nedgangen er at den generelle helsetilstanden i befolkningen er bedre, og at streptokokkbakteriene kanskje er blitt mindre farlige.
Enkelte får gjentatte og plagsomme halsbetennelser flere ganger per år. Ved flere enn fem akutte halsbetennelser, som helst skal ha vært vurdert og dokumentert av lege kan det være aktuelt å vurdere operasjon hvor man fjerner mandlene. Også ved færre halsbetennelser, men komplikasjoner som flere enn én halsbyll, kan det være hensiktsmessig å vurdere inngrepet.
Barnehage/dagmamma
Smittefaren er over dagen etter at behandlingen er startet. Barna kan da gå i barnehage dersom de ikke har feber over 38 grader eller svekket allmenntilstand. Ved tvil anbefales lav terskel for å holde barnet hjemme én eller to ekstra dag(er).
Dette dokumentet er basert på det profesjonelle dokumentet Streptokokkhalsinfeksjon . Referanselisten for dette dokumentet vises nedenfor
- Oliver J, Wadu EM, Pierse N, et al. Group A Streptococcus pharyngitis and pharyngeal carriage: A meta-analysis. PLoS Negl Trop Dis 2018; 12(3): e0006335. PMID: 29554121 PubMed
- Newberger R, Hollingshead CM. Group A Streptococcal Infections. [Updated 2025 Jan 14]. In: StatPearls [Internet]. Treasure Island (FL): StatPearls Publishing; 2025 Jan www.ncbi.nlm.nih.gov
- Folkehelseinstituttet. Invasive infeksjoner, årsrapport 2017. www.fhi.no
- Smittevernhåndboka. Streptokokk gruppe A-infeksjon – håndbok for helsepersonell. Siden sist oppdatert 09.07.2025. www.fhi.no
- Oppegaard O. Aktuelle trender for alvorlige betahemolytiske streptokokk-infeksjoner. Indremedisineren 2025. Publisert 10. okt. 2025. indremedisineren.no
- Helsedirektoratet. Streptokokkhalsinfeksjon og skarlagensfeber. Antibiotika i primærhelsetjenesten. Sist faglig oppdatert 24.6.2025. www.helsedirektoratet.no
- Shankarr S, Klingenberg C, Døllner H. Akutt tonsillitt og skarlagensfeber. Akutt veileder i pediatri. Fra Norsk barnelegeforening. Sist faglig oppdatert 01.11.2022. www.helsebiblioteket.no
- Little P, Hobbs FD, Moore M, et al.; PRISM Investigators. Clinical score and rapid antigen detection test to guide antibiotic use for sore throats: randomised controlled trial of PRISM (primary care streptococcal management). BMJ. 2013;347:f5806.
- National Institute for Health and Care Excellence (NICE). Sore Throat (acute): antimicrobial prescribing. NICEguidance [NG84]. Published date: January 2018. www.nice.org.uk
- Little P, Hobbs FD, Moore M. et al. Clinical score and rapid antigen detection test to guide antibiotic use for sore throats: randomised controlled trial of PRISM (primary care streptococcal management). BMJ 2013; 347: f5806. doi:10.1136/bmj.f5806 DOI
- Shaikh N, Swaminathan N, Hooper EG. Accuracy and precision of the signs and symptoms of streptococcal pharyngitis in children: a systematic review. J Pediatr 2012; 160: 487-93. PubMed
- Legeforeningen. Gjør kloke valg. Norsk forening for allmennmedisin. Unngå å ta CRP og hurtigtest for streptokokker før indikasjonen har blitt vurdert av lege. 26.6.2024. www.legeforeningen.no
- Folkehelseinstituttet. Smittevernveilederen. Streptokokk gruppe A-infeksjon – veileder for helsepersonell. Oppdatert 09.02.2024. Siden lest 25.03.2024. www.fhi.no
- Høye S, Fossum GH. Streptokokkhalsinfeksjon og skarlagensfeber. Nasjonale faglige retningslinjer for antibiotikabruk i primærhelsetjenesten. Oslo: Helsedirektoratet, sist oppdatert 16.06.2020. www.antibiotikaiallmennpraksis.no
- Worrall G, Hutchinson J, Sherman G, Griffiths J. Diagnosing streptococcal sore throat in adults: randomized controlled trial of in-office aids. Can Fam Physician 2007; 53: 666-71. PubMed
- Flatby AV, Evensen LH, Hafstad E. Beskrivelse og kvalitetsvurdering av retningslinjer for tonsillektomi ved tilbakevendende tonsillitt: forenklet metodevurdering og -kartlegging. Oslo: Folkehelseinstituttet, 2021 www.fhi.no
- van Driel ML, De Sutter AIM, Thorning S, Christiaens T. Different antibiotic treatments for group A streptococcal pharyngitis. Cochrane Database of Systematic Reviews 2021, Issue 3. The Cochrane Library
- de Cassan S, Thompson MJ, Perera R, et. al. Corticosteroids as standalone or add-on treatment for sore throat. Cochrane Database Syst Rev. 2020 May 1;PMID: 32356360 PubMed
- Burton MJ, Glasziou PP, Chong LY, Venekamp RP. Tonsillectomy or adenotonsillectomy versus non-surgical treatment for chronic/recurrent acute tonsillitis. Cochrane Database of Systematic Reviews 2014, Issue 11. Art. No.: CD001802. DOI: 10.1002/14651858.CD001802.pub3. DOI
- Koskenkorva T, Koivunen P, Koskela M, et al. Short-term outcomes of tonsillectomy in adult patients with recurrent pharyngitis: a randomized controlled trial. CMAJ 2013 May 14;185(8):E331-6. doi: 10.1503/cmaj.121852. DOI
- Bejerot S, Bruno K, Gerland G, et al. Misstänk PANDAS hos barn med akuta neuropsykiatriska symptom. Läkartidningen 2013; 110: CDCD. PMID: 24187894 PubMed